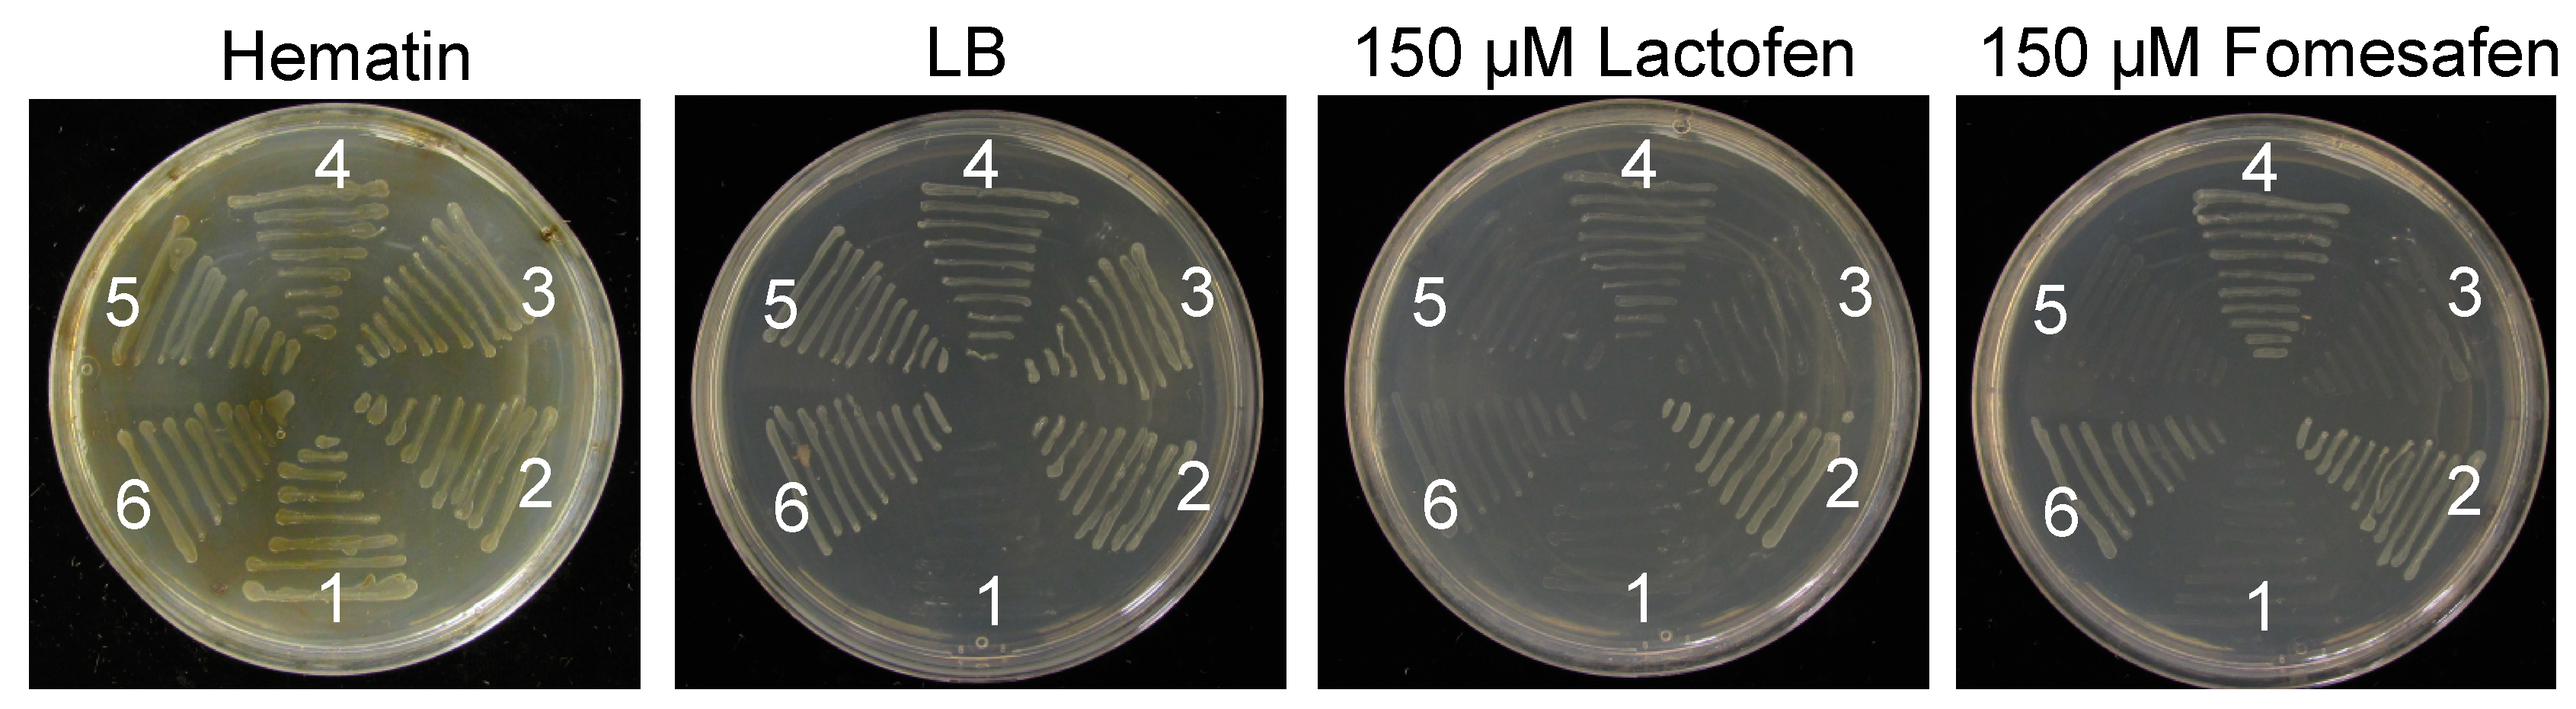
Plants 12 01886 g003 Plants 12 01886 g003

A New V361A Mutation in Amaranthus palmeri PPX2 Associated with PPO-Inhibiting Herbicide Resistance
Abstract
1. Introduction
2. Results
2.1. ∆G210 and R128 Mutation Frequency in A. palmeri Populations
2.2. Whole Plant Dose–Response
2.3. Investigation of Alternative Resistance Mechanisms
2.3.1. Three Substitutions Were Revealed in PPO-R Resistant AL Plants
2.3.2. V361A Substitution Was Identified to Be Associated with PPO-R Trait in Functional Complementation Analysis
2.3.3. The Resistant Level of PPX2 with V361A Substitution Is Less Than PPX2∆G210 in E. coli System
3. Discussion
3.1. Low Frequency of ∆G210 and R128 Mutation in PPO-R A. palmeri Survey
3.2. V361A Substitution in PPX2 Confers PPO-R Trait in PPO-R A. palmeri
4. Materials and Methods
4.1. Plant Material and Initial PPO-Inhibitor Resistance Screening
4.2. Whole Plant Dose Response to Fomesafen
4.3. Investigation of Alternative Resistance Mechanisms
4.3.1. cDNA Clone Amplification and Protein Alignment Analysis
4.3.2. Functional Complementation Analysis
4.3.3. Comparison of the Resistance Level between G210 Deletion and V361A in PPX2 in E. coli System
Supplementary Materials
Author Contributions
Funding
Data Availability Statement
Acknowledgments
Conflicts of Interest
References
- Jacobs, J.M.; Jacobs, N.J. Protoporphyrinogen oxidation, an enzymatic step in heme and chlorophyll synthesis: Partial characterization of the reaction in plant organelles and comparison with mammalian and bacterial systems. Arch. Biochem. Biophys. 1984, 229, 312–319. [Google Scholar] [CrossRef]
- Jacobs, J.M.; Jacobs, N.J. Porphyrin Accumulation and Export by Isolated Barley (Hordeum vulgare) Plastids (Effect of Diphenyl Ether Herbicides). Plant. Physiol. 1993, 101, 1181–1187. [Google Scholar] [CrossRef] [PubMed]
- Duke, S.O.; Lydon, J.; Becerril, J.M.; Sherman, T.D.; Lehnen, L.P., Jr.; Matsumoto, H. Protoporphyrinogen Oxidase-Inhibiting Herbicides. Weed Sci. 1991, 39, 465–473. [Google Scholar] [CrossRef]
- Lermontova, I.; Kruse, E.; Mock, H.-P.; Grimm, B. Cloning and characterization of a plastidal and a mitochondrial isoform of tobacco protoporphyrinogen IX oxidase. Proc. Natl. Acad. Sci. USA 1997, 94, 8895–8900. [Google Scholar] [CrossRef] [PubMed]
- Watanabe, N.; Che, F.S.; Iwano, M.; Takayama, S.; Yoshida, S.; Isogai, A. Dual targeting of spinach protoporphyrinogen oxidase II to mitochondria and chloroplasts by alternative use of two in-frame initiation codons. J. Biol. Chem. 2001, 276, 20474–20481. [Google Scholar] [CrossRef]
- Patzoldt, W.L.; Hager, A.G.; McCormick, J.S.; Tranel, P.J. A codon deletion confers resistance to herbicides inhibiting protoporphyrinogen oxidase. Proc. Natl. Acad. Sci. USA 2006, 103, 12329–12334. [Google Scholar] [CrossRef]
- Salas, R.A.; Burgos, N.R.; Tranel, P.J.; Singh, S.; Glasgow, L.; Scott, R.C.; Nichols, R.L. Resistance to PPO-inhibiting herbicide in Palmer amaranth from Arkansas. Pest. Manag. Sci. 2016, 72, 864–869. [Google Scholar] [CrossRef]
- Rousonelos, S.L.; Lee, R.M.; Moreira, M.S.; VanGessel, M.J.; Tranel, P.J. Characterization of a Common Ragweed (Ambrosia artemisiifolia) Population Resistant to ALS-and PPO-Inhibiting Herbicides. Weed Sci. 2012, 60, 335–344. [Google Scholar] [CrossRef]
- Giacomini, D.A.; Umphres, A.M.; Nie, H.; Mueller, T.C.; Steckel, L.E.; Young, B.G.; Scott, R.C.; Tranel, P.J. Two new PPX2 mutations associated with resistance to PPO-inhibiting herbicides in Amaranthus palmeri. Pest. Manag. Sci. 2017, 73, 1559–1563. [Google Scholar] [CrossRef] [PubMed]
- Steppig, N.R.; Mansfield, B.C.; Nie, H.Z.; Young, J.M.; Young, B.G. Presence of an Alternative Mechanism of Resistance to PPO-Inhibiting Herbicides in Tall Waterhemp Populations from Indiana, Illinois, Iowa, Missouri, and Minnesota. In Proceedings of the 72nd Annual Meeting of the North Central Weed Science Society, St. Louis, MO, USA, 4–7 December 2017; NCWSS Abstract. Volume 63. [Google Scholar]
- Nie, H.Z.; Mansfield, B.C.; Harre, N.T.; Young, J.M.; Steppig, N.R.; Young, B.G. InvestigatingTarget-Site Resistance to PPO-Inhibiting Herbicide Fomesafen in Waterhemp and Interspecific Hybridization of Amaranthus species Using Next Generation Sequencing. Pest. Manag. Sci. 2019, 75, 3235–3244. [Google Scholar] [CrossRef]
- Rangani, G.; Salas-Perez, R.A.; Aponte, R.A.; Knapp, M.; Craig, I.R.; Mietzner, T.; Langaro, A.C.; Noguera, M.M.; Porri, A.; Roma-Burgos, N. A novel single-site mutation in the catalytic domain of protoporphyrinogen oxidase ix (PPO) confers resistance to ppo-inhibiting herbicides. Front. Plant. Sci. 2019, 10, 568. [Google Scholar] [CrossRef]
- Montgomert, J.S.; Giacomini, D.A.; Tranel, P.J. Molecular confirmation of resistance to PPO inhibitors in Amaranthus tuberculatus and Amaranthus palmeri, and isolation of the G399A PPO2 substitution in A. palmeri. Weed Technol. 2020, 35, 99–105. [Google Scholar] [CrossRef]
- Dayan, F.E.; Daga, P.R.; Duke, S.O.; Lee, R.M.; Tranel, P.J.; Doerksen, R.J. Biochemical and structural consequences of a glycine deletion in the α-8 helix of protoporphyrinogen oxidase. BBA-Proteins Proteom. 2010, 1804, 1548–1556. [Google Scholar] [CrossRef] [PubMed]
- Hao, G.-F.; Tan, Y.; Yang, S.-G.; Wang, Z.-F.; Zhan, C.-G.; Xi, Z.; Yang, G.-F. Computational and Experimental Insights into the Mechanism of Substrate Recognition and Feedback Inhibition of Protoporphyrinogen Oxidase. PLoS ONE 2013, 8, e69198. [Google Scholar] [CrossRef]
- Koch M, Breithaupt C, Kiefersauer R, Freigang J, Huber R, and Messerschmidt A, Crystal structure of protoporphyrinogen IX oxidase: A key enzyme in haem and chlorophyll biosynthesis. EMBO J. 2004, 23, 1720–1728. [CrossRef] [PubMed]
- Volrath, S.L.; Johnson, M.A.; Ward, E.R.; Heifetz, P.B. DNA Molecules Encoding Plant Protoporphyrinogen Oxidase and Inhibitor-Resistant Mutants Thereof. U.S. Patent US5939602A, 17 August 1999. [Google Scholar]
- Li, X.; Volrath, S.L.; Nicholl, D.B.; Chilcott, C.E.; Johnson, M.A.; Ward, E.R.; Law, M.D. Development of protoporphyrinogen oxidase as an efficient selection marker for Agrobacterium tumefaciens-mediated transformation of maize. Plant. Physiol. 2003, 133, 736–747. [Google Scholar] [CrossRef] [PubMed]
- Randolph-Anderson, B.L.; Sato, R.; Johnson, A.M.; Harris, E.H.; Hauser, C.R.; Oeda, K.; Ishige, F.; Nishio, S.; Gillham, N.W.; Boynton, J.E. Isolation and characterization of a mutant protoporphyrinogen oxidase gene from Chlamydomonas reinhardtii conferring resistance to porphyric herbicides. Plant. Mol. Biol. 1998, 38, 839–859. [Google Scholar] [CrossRef]
- Heap, I. The International Survey of Herbicide Resistant Weeds. 2022. Available online: http://www.weedscience.org (accessed on 1 February 2022).
- Shoup, D.E.; Al-Khatib, K.; Peterson, D.E. Common Waterhemp (Amaranthus rudis) Resistance to Protoporphyrinogen Oxidase-Inhibiting Herbicides. Weed Sci. 2003, 51, 145–150. [Google Scholar] [CrossRef]
- Thinglum, K.A.; Riggins, C.W.; Davis, A.S.; Bradley, K.W.; Al-Khatib, K.; Tranel, P.J. Wide Distribution of the Waterhemp (Amaranthus tuberculatus) ΔG210 PPX2 Mutation, which Confers Resistance to PPO-Inhibiting Herbicides. Weed Sci. 2011, 59, 22–27. [Google Scholar] [CrossRef]
- Salas-Perez, R.A.; Burgos, N.R.; Rangani, G.; Singh, S.; Paulo Refatti, J.; Piveta, L.; Tranel, P.J.; Mauromoustakos, A.; Scott, R.C. Frequency of Gly-210 Deletion Mutation among Protoporphyrinogen Oxidase Inhibitor–Resistant Palmer Amaranth (Amaranthus palmeri) Populations. Weed Sci. 2017, 65, 718–731. [Google Scholar] [CrossRef]
- Varanasi, V.K.; Brabham, C.; Norsworthy, J.K.; Nie, H.; Young, B.G.; Houston, M.; Barber, T.; Scott, R.C. A Statewide Survey of PPO-Inhibitor Resistance and the Prevalent Target-Site Mechanisms in Palmer amaranth (Amaranthus palmeri) Accessions from Arkansas. Weed Sci. 2017, 66, 149–158. [Google Scholar] [CrossRef]
- Noguera, M.M.; Rangani, G.; Heiser, J.; Bararpour, T.; Steckel, L.E.; Betz, M.; Porri, A.; Lerchl, J.; Zimmermann, S.; Nichols, R.L.; et al. Functional PPO2 mutations: Co-occurrence in one plant or the same ppo2 allele of herbicide resistant Amaranthus palmeri in the US mid-south. Pest. Manag. Sci. 2020, 77, 1001–1012. [Google Scholar] [CrossRef] [PubMed]
- Mansfield, B.C.; Nie, H.Z.; Young, J.M.; Bradley, K.M.; Young, B.G. A Multi-State Survey to Determine the Potential for Resistance to PPO-Inhibiting Herbicides in Tall Waterhemp Beyond the G210 Target Site Mutation. In Proceedings of the 72nd Annual Meeting of the North Central Weed Science Society, St. Louis, MO, USA, 4–7 December 2017; NCWSS Abstract. Volume 62. [Google Scholar]
- Doyle and, J. J, A rapid DNA isolation procedure for small quantities of fresh leaf tissue. Phytochem. Bull. 1987, 19, 11–15. [Google Scholar]
- Wuerffel, R.J.; Young, J.M.; Lee, R.M.; Tranel, P.J.; Lightfoot, D.A.; Young, B.G. Distribution of the ΔG210 Protoporphyrinogen Oxidase Mutation in Illinois Waterhemp (Amaranthus tuberculatus) and an Improved Molecular Method for Detection. Weed Sci. 2015, 63, 839–845. [Google Scholar] [CrossRef]
- Ritz, C.; Baty, F.; Streibig, J.C.; Gerhard, D. Dose-Response Analysis Using R. PLoS ONE 2015, 10, e0146021. [Google Scholar] [CrossRef] [PubMed]
- Stevan, Z.; Knezevic, J.C.; Streibig, C.R. Utilizing R Software Package for Dose-Response Studies: The Concept and Data Analysis. Weed Technol. 2007, 21, 840–848. [Google Scholar]

| State | Locations a | Individual Genotypes b | |||
|---|---|---|---|---|---|
| Total | Resistant | Homozygous Resistant | Heterozygous Resistant | Susceptible | |
| Alabama | 6 | 0 | 0 | 0 | 83 |
| Arkansas | 3 | 3 | 1 | 6 | 7 |
| Illinois | 1 | 1 | 0 | 2 | 3 |
| Indiana | 2 | 0 | 0 | 0 | 6 |
| Missouri | 3 | 1 | 2 | 1 | 11 |
| Mississippi | 32 | 2 | 0 | 5 | 808 |
| North Carolina | 5 | 0 | 0 | 0 | 44 |
| South Carolina | 3 | 0 | 0 | 0 | 28 |
| Tennessee | 29 | 10 | 5 | 54 | 762 |
| Data | Population | GR50 Estimate | ||
|---|---|---|---|---|
| Value | Standard Error | R/S Value | ||
| Fresh weight | g ha-1 | |||
| Susceptible | 4.0 | 0.8 | ||
| Resistant with ∆G210 | 8.9 | 2.4 | 2.4 | |
| AL resistant | 13.9 | 3.4 | 3.5 | |
| Dry weight | Susceptible | 1.8 | 0.4 | |
| Resistant with ∆G210 | 3.6 | 1.6 | 2.0 | |
| AL resistant | 5.6 | 2.1 | 3.1 | |
Disclaimer/Publisher’s Note: The statements, opinions and data contained in all publications are solely those of the individual author(s) and contributor(s) and not of MDPI and/or the editor(s). MDPI and/or the editor(s) disclaim responsibility for any injury to people or property resulting from any ideas, methods, instructions or products referred to in the content. |
© 2023 by the authors. Licensee MDPI, Basel, Switzerland. This article is an open access article distributed under the terms and conditions of the Creative Commons Attribution (CC BY) license (https://creativecommons.org/licenses/by/4.0/).
Share and Cite
Nie, H.; Harre, N.T.; Young, B.G. A New V361A Mutation in Amaranthus palmeri PPX2 Associated with PPO-Inhibiting Herbicide Resistance. Plants 2023, 12, 1886. https://doi.org/10.3390/plants12091886
Nie H, Harre NT, Young BG. A New V361A Mutation in Amaranthus palmeri PPX2 Associated with PPO-Inhibiting Herbicide Resistance. Plants. 2023; 12(9):1886. https://doi.org/10.3390/plants12091886
Chicago/Turabian StyleNie, Haozhen, Nick T. Harre, and Bryan G. Young. 2023. "A New V361A Mutation in Amaranthus palmeri PPX2 Associated with PPO-Inhibiting Herbicide Resistance" Plants 12, no. 9: 1886. https://doi.org/10.3390/plants12091886
APA StyleNie, H., Harre, N. T., & Young, B. G. (2023). A New V361A Mutation in Amaranthus palmeri PPX2 Associated with PPO-Inhibiting Herbicide Resistance. Plants, 12(9), 1886. https://doi.org/10.3390/plants12091886

